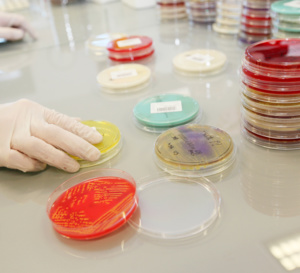
Médicaments et microbiote, données inédites …

INFOS INDUSTRIELES
Les News
Au Sénégal, un médicament générique africain fait naître un nouvel espoir contre la drépanocytose.
03/07/2026
- senesante.com
Hormonothérapie et Cancer de la Prostate : bénéfices du traitement et gestion des effets secondaires.
18/06/2026
- senesante.com
SYMPOSIUM SUR LA PRISE EN CHARGE DE L'ANEMIE FERIPRIVE CE 18 JUIN 2026 À 15H 30
18/06/2026
- senesante.com
Lutte contre le VIH : Le Lenacapavir, l’injection semestrielle qui promet 100 % de protection, est lancé en Afrique du Sud
13/06/2026
- senesante.com
𝟐𝟒 𝐌𝐚𝐫𝐬 𝟐𝟎𝟐𝟔, 𝐉𝐨𝐮𝐫𝐧𝐞́𝐞 𝐦𝐨𝐧𝐝𝐢𝐚𝐥𝐞 𝐝𝐞 𝐥𝐮𝐭𝐭𝐞 𝐜𝐨𝐧𝐭𝐫𝐞 𝐥𝐚 𝐓𝐮𝐛𝐞𝐫𝐜𝐮𝐥𝐨𝐬𝐞
24/03/2026
- senesante.com
Joyeux Aïd el-Fitr de la part de Senesante !
21/03/2026
- senesante.com
Hormonothérapie et Cancer de la Prostate : bénéfices du traitement et gestion des effets secondaires.
18/06/2026
Eviter le foie gras, la cirrhose et maintenir son foie en bonne santé
08/12/2023
Soigner son intestin et son microbiote pour une meilleure santé ? L’importance du dépistage
08/12/2023
Tout sur la santé bucco dentaire
12/11/2022
AVC (Accident Vasculaire Cérébral) : Causes, Symptômes et Traitements
01/09/2022
Galerie